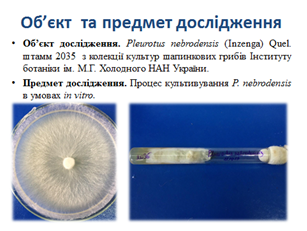

Попередній захист випускних бакалаврських робіт студентів денної форм навчання спеціальності «Біотехнології та біоінженерія»
28 травня на кафедрі екобіотехнології та біорізноманіття було проведено розширене он-лайн засідання, на якому відбувся попередній захист випускних бакалаврських робіт студентів денної форм навчання спеціальності «Біотехнології та біоінженерія».
Засідання із словами підтримки розпочав завідувач кафедри екобіотехнології та біорізноманіття д.с.-г.н., проф., член-кореспондент НААН України Микола Патика. На засіданні були присутні д.с.-г.н., проф. кафедри Оксана Кляченко, д.с.-г.н., доцент Віра Бородай, д.с.-г.н., професор кафедри молекулярної біології, мікробіології та біобезпеки Микола Лісовий, завідувач кафедри фізіології, біохімії рослин та біоенергетики, к.б.н., доцент Ольга Бойко, т.в.о. декана факультету захисту рослин біотехнологій та екології д.с.-г.н., доцент Юлія Коломієць, заступник декана факультету ЗРБтаЕ, к.іст.н., доцент кафедри фізіології, біохімії рослин та біоенергетики Петро Дрозд, асистент кафедри фізіології, біохімії рослин та біоенергетики, к.с.-г.н. Анна Дащенко.

Завідувач кафедри, професор Микола Патика повідомив, що відповідно до «Положення про порядок написання та захисту випускних бакалаврських робіт» всі роботи успішно пройшли перевірку на плагіат.

На попередньому захисті було заслухано 32 студентів, кожен з яких коротко доповів про актуальність, мету, завдання, методи досліджень та результати проведених експериментів.


За кожної доповіді проводили дискусію, студенти відповідали про актуальність теми досліджень, вибір об’єктів та предметів досліджень.


Кожен з майбутніх біотехнологів захищав новизну проведених експериментів і показував свої знання з широкого кола дисциплін, як от: загальна і промислова біотехнологія, мікробіологія, вірусологія, фізіологія рослин та інших. Заслуговують на особливу увагу одні з найсучасніших біотехнологічних тем, що були висвітлені на передзахисті: «Створення генетичних конструкцій для отримання біотехнологічних ліній кукурудзи, стійких до гліфосфату та діабротики» (Марина Дзуг, науковий керівник – доцент Катерина Гринчук), “Отримання дигаплоїдів ріпаку гібридів F1 для прискорення селекційного процесу” (Лілія Дудка, науковий керівник – доцент Ігор Антіпов).


Найактуальнішими на сьогодні є такі напрями досліджень, як «Використання молекулярно-біологічних маркерів для вивчення генів стійкості пшениці ярої та озимої до бурої іржі, піренофорозу та фузаріозу колоса» (Ілля Кучерявий, науковий керівник – доцент Віра Бородай).

Окремим напрямком йшли дослідження з особливостей культивування рослин в умовах in vitro, проведені Вікторією Двороківською, Єлизаветою Бережною, Андрієм Романенко, Юлією Бученко та іншими студентами під керівництвом Оксани Лобової, Юлії Коломієць, Віри Бородай). Особливо хочеться відмітити групу студентів Світлану Ширченко, Анастасію Савенко, Дениса Зленко та інших, які під керівництвом доцента Ольги Бойко вивчали особливості росту видів базидіальних грибів роду Pleurotus та інших грибів, а також Дар’ї Метейко, що досліджувала особливості культивування штаму-продуценту вітаміну В2 (рибофлавіну) Bacillus subtilis на базі Інституту харчової біотехнології та геноміки.
Керівники бакалаврських робіт висловили свої побажання щодо удосконалення презентацій та написання бакалаврських робіт, які вже знаходяться на завершальному етапі.
У результаті проведення попереднього захисту всі студенти денної форми навчання допущені до захисту бакалаврських робіт, який заплановано на 15-16 червня в онлайн форматі.
Віра Бородай
доцент кафедри екобіотехнології та біорізноманіття